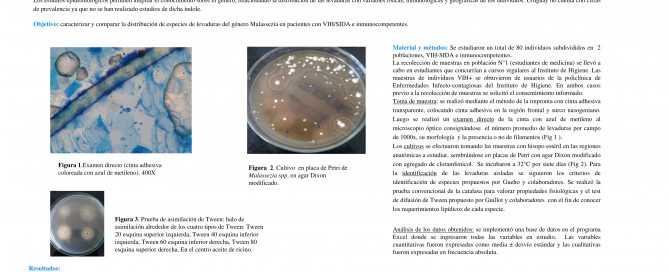

Avada includes a blog shortcode you can use anywhere on the site!
[FVET] Interferencia de la Leucosis bovina enzoótica en la respuesta inmune de bovinos inmunizados contra Fiebre Aftosa a campo.
Leucosis Bovina Enzoótica (LBE) es una enfermedad infecciosa crónica e inmunosupresora causada por un retrovirus bovino. El virus de la fiebre aftosa (FMD) produce una enfermedad altamente contagiosa que afecta biungulados domésticos y salvajes. El [...]
[FMED] Aislamiento e Identificación de levaduras del género Malassezia en individuos VIH/SIDA e inmunocompetentes.
Estudiantes: Annie Arrillaga Victoria Cabó, Cecilia Martinez, Tatiana Sellanes. Docente orientador: Prof. Agda. Dra. Zaida Arteta Docente co-orientador: Prof. Adj Patricia Perera Servicio: Depto. de Parasitología y Micología. Facultad de Medicina. UdelaR. Las levaduras del [...]
[FAGRO] Uso de extractos de plantas para el control de Clavibacter michiganensis subsp. michiganensis en tomate
El cancro bacteriano en tomate, causado por Clavibacter michiganensis subsp. michiganensis, es una enfermedad de gran importancia en nuestro país. Las herramientas de control de esta enfermedad son muy escasas. Este trabajo se propone generar [...]